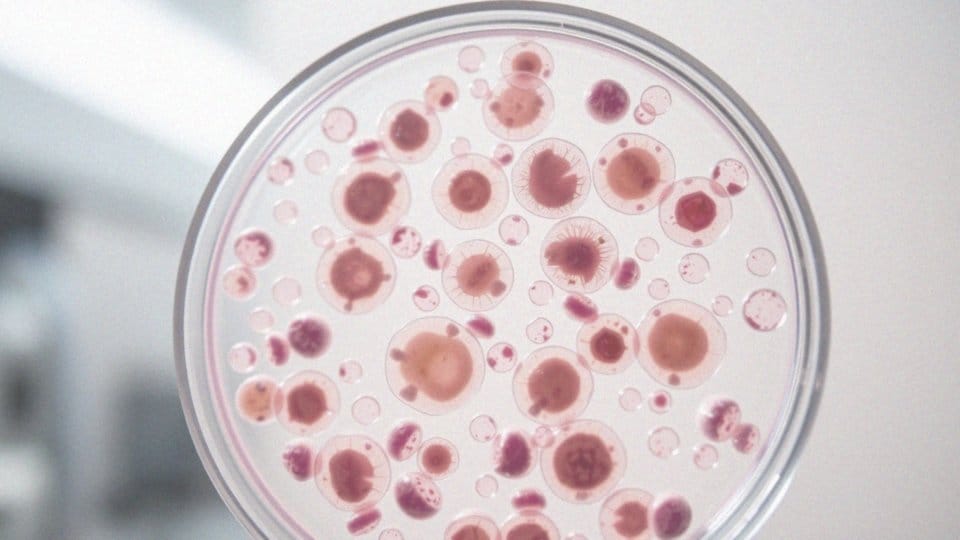
Jak pierzga wpływa na nowotwory?

Spis treści
Co to jest pierzga i jakie ma właściwości zdrowotne?
Pierzga to wyjątkowy pyłek kwiatowy, który pszczoły zbierają, łącząc go z innymi produktami swojej pracy i poddając procesowi fermentacji mlekowej. Jest to naturalny skarb obfitujący w liczne korzystne dla zdrowia właściwości. Pierzga wypełniona jest cennymi składnikami odżywczymi, takimi jak:
- białka,
- witaminy (w tym C, B oraz E),
- minerały (takie jak cynk, magnez, i żelazo),
- kwasy tłuszczowe.
Imponujące właściwości tego produktu przyczyniają się do wsparcia układu immunologicznego, wzmacniając jego zdolność do walki z infekcjami. Dodatkowo, wysoka zawartość przeciwutleniaczy sprawia, że pierzga działa antyoksydacyjnie, co jest korzystne dla zdrowia komórek oraz efektywnej walki z wolnymi rodnikami.
Regularne włączanie pierzgi do diety jako suplementu może także wpływać pozytywnie na funkcje jelit oraz obniżanie poziomu cholesterolu, co z kolei wspiera sercowo-naczyniowy system organizmu. W związku z tym, pierzga zyskuje na popularności w kontekście zdrowotnej profilaktyki oraz jako wsparcie dla organizmu w zmaganiach z chorobami nowotworowymi.
Badania sugerują, że jej regularne spożycie może przyczynić się do efektywności terapii terapeutycznych i pozytywnie oddziaływać na zdrowie pacjentów chorujących na nowotwory.
Jakie składniki odżywcze zawiera pierzga?
Pierzga, znana również jako pyłek pszczeli, jest prawdziwą skarbnicą bogactwa składników odżywczych, które odgrywają kluczową rolę w poprawie zdrowia i wsparciu metabolizmu. Przyjrzyjmy się najważniejszym z nich:
- Białka – Otrzymujemy ich aż 30-40% z pierzgi, co jest niezwykle istotne dla regeneracji tkanek oraz produkcji enzymów i hormonów,
- Aminokwasy egzogenne – Zawiera wszystkie dziewięć aminokwasów, które nasz organizm musi pozyskać z pokarmu,
- Mikroelementy – Bogata w minerały, takie jak potas, wapń, magnez, żelazo, cynk i miedź, wspiera różne funkcje organizmu, między innymi wzmacnia kości i reguluje ciśnienie krwi,
- Witaminy – Szczególnie witaminy z grupy B, które są niezbędne dla naszego układu nerwowego oraz metabolizmu,
- Enzymy i koenzymy – Pełnią istotną rolę w wielu procesach biochemicznych, a także wspierają układ pokarmowy,
- Węglowodany i lipidy – Dostarczają energii, która jest kluczowa dla prawidłowego funkcjonowania ciała,
- Kwasy tłuszczowe – Zawierają zdrowe kwasy tłuszczowe, które korzystnie wpływają na zdrowie serca i układu krążenia,
- Polifenole – Działają jako potężne przeciwutleniacze, chroniąc nasze komórki przed szkodliwymi skutkami wolnych rodników.
Dzięki wysokiej przyswajalności wynoszącej około 80%, składniki pierzgi są łatwo wchłaniane przez organizm, co czyni ją szczególnie skutecznym suplementem diety. Regularne spożywanie tego naturalnego produktu może istotnie wpłynąć na nasz układ odpornościowy, wzmacniając jego zdolność do walki z chorobami, w tym nowotworami.
Jakie są możliwe reakcje alergiczne na pierzgę?
Pierzga, mimo swoich licznych wartości odżywczych, może powodować reakcje alergiczne. Dotyczy to szczególnie osób uczulonych na:
- pyłki kwiatowe,
- inne produkty pochodzenia pszczelego.
Objawy alergii mogą manifestować się w postaci:
- wysypki,
- świądu,
- obrzęku skóry.
W niektórych przypadkach mogą wystąpić poważniejsze dolegliwości, jak:
- trudności w oddychaniu,
- anafilaksja,
- które wymagają natychmiastowej interwencji medycznej.
Dlatego osoby z historią alergii powinny powstrzymać się od używania pierzgi. Natomiast ci, którzy nie mieli wcześniej styczności z tym produktem, powinni zaczynać od niewielkich ilości i dokładnie obserwować, jak ich organizm na nie reaguje. Dodatkowo, warto zasięgnąć porady lekarza przed rozpoczęciem suplementacji pierzgą, co jest istotne w kontekście profilaktyki chorób przewlekłych oraz nowotworów. Pamiętajmy, że bezpieczeństwo stosowania pierzgi jest niezwykle ważne, mimo wszystkich jej potencjalnych korzyści zdrowotnych.
Jakie są korzyści ze stosowania pierzgi w profilaktyce nowotworowej?
Pierzga pszczela ma niezwykle istotne znaczenie w profilaktyce nowotworowej, głównie dzięki swoim silnym właściwościom antyoksydacyjnym. Zawiera składniki, które skutecznie neutralizują wolne rodniki, co przekłada się na zmniejszenie stresu oksydacyjnego. W rezultacie pomaga w ochronie komórek przed uszkodzeniem DNA. Liczne badania wskazują, że pierzga potrafi:
- hamować rozwój komórek rakowych,
- aktywować apoptozę, czyli zaprogramowaną śmierć komórkową.
Jej korzystny wpływ na system immunologiczny odgrywa kluczową rolę w zapobieganiu nowotworom. Regularne spożywanie tego suplementu wzmacnia układ odpornościowy, co jest niezwykle ważne w kontekście walki z chorobami nowotworowymi. Co więcej, pierzga może również wspierać organizm podczas terapii, zwiększając skuteczność leczenia oraz łagodząc skutki uboczne. Zarówno tradycyjna medycyna ludowa, jak i nowoczesne badania dostarczają dowodów na to, że włączenie pierzgi do diety może znacząco zredukować ryzyko wystąpienia nowotworów. Przyczynia się również do promowania zdrowego stylu życia. Włączenie pierzgi do codziennych nawyków, w połączeniu z innymi zdrowymi praktykami, może być wartościowym krokiem w strategii zapobiegania nowotworom.
Jakie badania kliniczne dotyczące pierzgi przeprowadzono?
Badania kliniczne dotyczące pierzgę stają się coraz bardziej istotne w kontekście terapii nowotworowej. Wyniki przeprowadzonych badań na pacjentach onkologicznych wskazują na obiecujące rezultaty jej stosowania jako uzupełnienia tradycyjnych metod leczenia. Analizy zarówno in vitro, jak i in vivo sugerują, że pierzga ma potencjał w działaniu przeciwnowotworowym.
- jej właściwości mogą aktywować apoptozę komórek rakowych,
- obniżać stres oksydacyjny, kluczowy proces w rozwoju nowotworów.
Włączenie pierzgi do codziennej diety może wspierać organizm w walce z chorobą oraz podnosić efektywność terapii. Ważne jest jednak zaznaczenie, że aby w pełni potwierdzić jej skuteczność i bezpieczeństwo w leczeniu nowotworów, konieczne są dokładniejsze badania kliniczne. Mimo obiecujących wyników, potrzebne są większe grupy badawcze oraz dłuższe okresy obserwacji, by móc sformułować ostateczne wnioski w kwestii jej właściwości terapeutycznych. Kontynuowanie badań nad pierzgą jest kluczowe dla zrozumienia jej możliwych korzyści zdrowotnych i roli w onkologii.
Jak działanie antyoksydacyjne pierzgi wspiera leczenie nowotworów?
Antyoksydacyjne właściwości pierzgi pełnią niezwykle ważną rolę w walce z nowotworami. Pomagają one w redukcji stresu oksydacyjnego, który może prowadzić do uszkodzeń komórek i sprzyjać rozwojowi chorób nowotworowych.
Wolne rodniki, będące efektem metabolizmu, przyczyniają się do mutacji komórkowych, a nawet mogą wywoływać śmierć zdrowych komórek. Dzięki przeciwutleniaczom obecnym w pierzdze, organizm jest w stanie neutralizować te szkodliwe składniki, co chroni DNA i wspiera funkcjonowanie komórek.
Stałe wprowadzanie pierzgi do diety może ograniczać uszkodzenia komórek, które często są wynikiem intensywnych terapii onkologicznych, takich jak:
- chemioterapia,
- radioterapia.
W rezultacie, pacjenci mogą lepiej znosić leczenie, co znacząco zwiększa jego skuteczność. To jest szczególnie istotne w kontekście całościowej opieki nad osobami chorymi na raka. Dodatkowo, pierzga wzmacnia układ odpornościowy, co podnosi zdolność organizmu do walki z komórkami rakowymi.
Liczne badania i obserwacje potwierdzają, że suplementacja tym specyfikiem przynosi realne korzyści w terapii nowotworowej, co podkreśla jej potencjał w nowoczesnym leczeniu onkologicznym.
Jak pierzga wpływa na nowotwory?
Pierzga odgrywa kluczową rolę w walce z chorobami nowotworowymi, głównie dzięki swoim właściwościom przeciwnowotworowym. Zawarte w niej składniki skutecznie stymulują proces apoptozy komórek nowotworowych, co jest niezbędne dla eliminacji zainfekowanych komórek. Co więcej, pierzga ogranicza proliferację komórek rakowych, a tym samym hamuje rozwój nowotworów. Dodatkowo, jej działanie obejmuje redukcję stresu oksydacyjnego, który może prowadzić do uszkodzeń komórkowych oraz transformacji nowotworowych.
Dzięki umiejętności neutralizowania wolnych rodników, pierzga chroni DNA komórek, wspierając ich prawidłowe funkcjonowanie. Nie można również pominąć jej wpływu na angiogenezę, proces kluczowy dla rozwoju guzów. Dzięki swoim właściwościom przeciwnowotworowym, ogranicza rozwój nowych naczyń krwionośnych, które zasilają nowotwory.
Co więcej, pierzga jest istotnym wsparciem dla układu odpornościowego, co ma ogromne znaczenie w walce z rakiem. Wzmacniając naturalne mechanizmy obronne organizmu, ten naturalny suplement przyczynia się do bardziej efektywnego zwalczania komórek rakowych. Regularne włączanie pierzgi do diety może także wspierać terapie i poprawiać skuteczność leczenia onkologicznego.
Jakie są działanie przeciwnowotworowe pierzgi pszczelej?
Pierzga pszczela charakteryzuje się licznymi właściwościami, które mogą przeciwdziałać rozwojowi nowotworów. Jej kluczowe działanie polega na:
- spowolnieniu wzrostu komórek rakowych,
- redukcji ich proliferacji,
- stymulacji procesu apoptozy, co przyczynia się do eliminacji komórek nowotworowych,
- zmniejszeniu ryzyka wystąpienia chorób nowotworowych,
- ograniczeniu angiogenezy, czyli tworzeniu nowych naczyń krwionośnych, które zasilają guzy w niezbędne składniki odżywcze,
- wzmacnianiu układu odpornościowego,
- zwiększeniu naturalnych mechanizmów obronnych organizmu,
- redukcji stresu oksydacyjnego.
Dodatkowo, pierzga neutralizuje wolne rodniki, co jest szczególnie istotne w kontekście ochrony komórek przed uszkodzeniami podczas leczenia nowotworowego. W literaturze można znaleźć wiele dowodów na skuteczność pierzgi w terapii różnych typów nowotworów, takich jak rak piersi, prostaty czy jelita grubego. Regularne włączanie pierzgi do diety może wspierać proces terapii nowotworowej, zwiększając jej efektywność oraz poprawiając komfort życia pacjentów.
W jaki sposób pierzga wspomaga terapię nowotworową?

Pierzga ma istotne znaczenie w kontekście terapii nowotworowej. Działa na organizm, pomagając mu radzić sobie z nieprzyjemnymi skutkami ubocznymi leczenia. Jej właściwości detoksykacyjne sprzyjają usuwaniu toksyn, co jest niezwykle istotne dla zdrowia wątroby. Dzięki wsparciu dla układu pokarmowego, pierzga działa kojąco na objawy, takie jak:
- utrata apetytu,
- nudności,
- które często towarzyszą chemioterapii i radioterapii.
Bogactwo składników odżywczych w pierzdze znacząco wpływa na regenerację organizmu, co w efekcie prowadzi do lepszego samopoczucia pacjentów. Ponadto, wyniki badań sugerują, że regularne przyjmowanie pierzgi może zmniejszać ryzyko infekcji, które są częstym problemem osób borykających się z nowotworami. Wzmacniając odporność, pierzga wspiera organizm w obronie przed komórkami rakowymi, co jest kluczowe w walce z chorobą. Jej działanie antyoksydacyjne pomaga w procesie leczenia, redukując stres oksydacyjny i wspierając regenerację uszkodzonych komórek. Dodatkowo, poprzez wspomaganie naturalnych mechanizmów obronnych organizmu, pierzga może przyczynić się do zwiększenia efektywności terapii, nawet w najbardziej wymagających okolicznościach. Dodanie pierzgi do diety osób walczących z rakiem może być wartościowym uzupełnieniem tradycyjnych metod leczenia.
Jakie są zalecane dawki pierzgi dla osób z nowotworem?
Dawkowanie pierzgi dla osób z nowotworami powinno być przede wszystkim dostosowane do indywidualnych potrzeb każdego pacjenta. Właściwe współdziałanie z lekarzem lub dietetykiem jest kluczowe w ustaleniu optymalnych dawek. Istotne jest, aby wziąć pod uwagę:
- rodzaj nowotworu,
- ogólny stan zdrowia.
Zwykle zaleca się spożycie od jednej do trzech łyżeczek dziennie. Najkorzystniej przyjmować pierzgę rano, na czczo lub przed posiłkiem, co zwiększa przyswajalność jej składników odżywczych. Rozpoczynając od niewielkich dawek, można zredukować ryzyko wystąpienia niepożądanych reakcji organizmu. Stopniowe zwiększanie ilości może przynieść lepsze efekty zdrowotne. Ważne jest również, aby nie przekraczać zalecanych dawek, gdyż nadmiar pierzgi może prowadzić do działań ubocznych.
Odpowiednia suplementacja tego preparatu wspiera funkcjonowanie układu odpornościowego oraz metabolizm pacjentów walczących z nowotworem. To z pewnością jest istotnym elementem skuteczności całej terapii. Regularne włączanie pierzgi do diety może korzystnie wpłynąć na ogólny stan zdrowia i wspierać walkę z tą groźną chorobą.
Jakie są synergistyczne efekty pierzgi z innymi substancjami leczniczymi?
Pierzga działa synergistycznie, szczególnie w połączeniu z innymi substancjami leczniczymi. Na przykład, zestawiona z propolisem oraz różnymi suplementami diety, ma potencjał wzmocnienia właściwości przeciwnowotworowych. Badania wykazują, że takie połączenia nie tylko zwiększają skuteczność terapii, ale również łagodzą negatywne skutki uboczne związane z leczeniem nowotworów.
Przyjmowanie pierzgi w trakcie chemioterapii może istotnie zmniejszyć toksyczność stosowanych leków, co przekłada się na lepszy komfort życia pacjentów. Dodatkowo, włączenie pierzgi do diety bogatej w antyoksydanty oraz regularna aktywność fizyczna mogą potęgować jej korzystny wpływ na zdrowie.
Antyoksydacyjne właściwości pierzgi skutecznie chronią komórki przed stresem oksydacyjnym, co jest niezwykle ważne w kontekście terapii nowotworowej. Takie kompleksowe podejście wspiera układ odpornościowy, zwiększając zdolność organizmu do walki z chorobami i stymulując regenerację komórek.
Dzięki synergistycznym efektom pierzgi oraz zdrowym nawykom, takim jak zbilansowana dieta, leczenie staje się bardziej efektywne. Regularne stosowanie tego naturalnego składnika ukazuje jego potencjał w poprawie efektywności terapii onkologicznych oraz korzystnych reakcji organizmu na leczenie. Warto rozważyć takie rozwiązania w kontekście wspierania ogólnego zdrowia.




